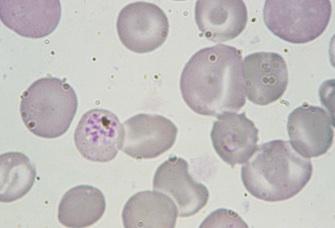

Etude du MIT
Un aimant pour détecter le paludisme
Des chercheurs ont découvert une nouvelle technique pour détecter le paludisme. Peu coûteuse, elle consiste à utiliser un outil magnétique, pemettant de détecter la gravité de l'infection.
- Par Léa Drouelle
- Commenting
- DURAND FLORENCE SIPA
Les techniques actuelles pour détecter diagnostiquer le paludismene ne sont pas fiables à 100 % et restent difficilement accessibles dans certaines régions d' Afrique, où l'infection fait des ravages. Elles consistent en effet à analyser un échantillon de sang disposé sur une lame de verre à l'aide d'un colorant chimique. Mais des équipes de chercheurs américains et singapouriens de The Singapore-MIT Alliance for Research and Technology (SMART) ont peut-être trouvé une nouvelle méthode plus efficace, et moins coûteuse. Leurs travaux sont publiés dans la revue Nature Medicine. Déchets de parasites « Nous avons essayer de déterminer la manière dont la résonance magnétique nucléaire de l'hydrogène est affectée par la proximité d'autres particules magnétiques, tels que les cristaux d'hémoziones », explique le Pr Han, l’un des auteurs de l’étude. Soumis à une puissance magnétique, les atomes d’hydrogène interfèrent avec les autres particules présentes. Une méthode plus fiable et moins chère Un test simple à réaliser et peu coûteux serait donc très précieux pour aider ces régions d'Afrique subsaharienne à lutter contre la maladie.
L’étude fait part d’une nouvelle méthode consistant à utiliser un outil proche de l’imagerie à résonnance magnétique (IRM) : la relaxométrie à résonnance magnétique nucléaire (RMN.) Grâce à cette technique, les chercheurs ont détecté la présence de déchets rejetés par le Plastonium, le parasite unicellulaire du paludisme dans les globules rouges. Ces déchets sont des cristaux d’hémozoine, aussi appelés "pigments malariques". La présence de ces particules permet de déterminer la gravité de l’infection.
Plus les "pigments malariques" sont présents, plus l’orientation des atomes d’hydrogène est perturbée par le champ magnétique. La RMN permettrait donc d’identifier plus facilement la présence de cristaux d’hémozoines dans les globules rouges. « Cette technique est plus fiable et plus facilement utilisable sur le terrain car elle se base sur l'analyse d'un biomarqueur naturel », précise le Pr Weng Kung Peng, auteur principal de l’étude.
Mais selon le Pr Peng, cette nouvelle méthode serait également plus rapide et moins coûteuse. « Il est possible de fabriquer pour moins de 2000 dollars, soit 1 500 euros, des versions plus petites et faciles à utiliser de ces appareils, ce qui reviendrait à un coût de moins de 10 cents par test », estiment les chercheurs. Chaque année, le paludisme fait plus de 600 000 morts, dont une majorité d’enfants qui vivent en Afrique subsaharienne.